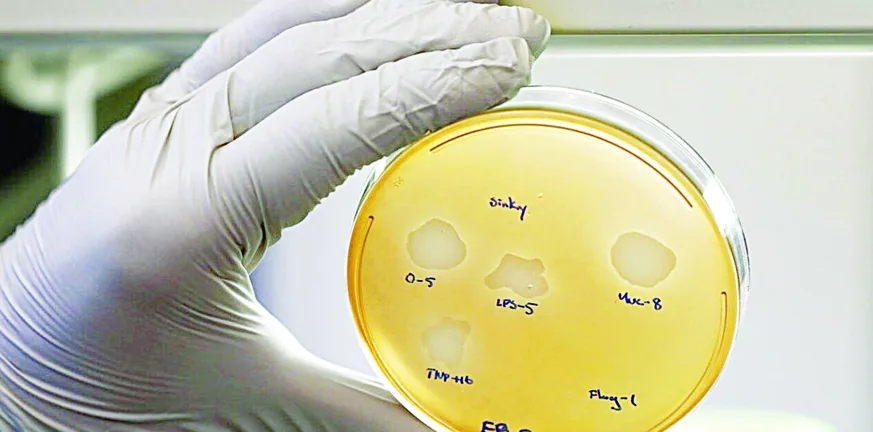

Πάτρα: Θρέφουμε την αντοχή στα μικρόβια – Τι έδειξαν τα λύματα της πόλης
Σημάδια μικροβιακής αντοχής στα αντιβιοτικά καταγράφηκαν στα αστικά λύματα της Πάτρας, μέσα από μελέτη του Εργαστηρίου Υγιεινής του Πανεπιστημίου Πατρών σε συνεργασία με το Τεχνικό Πανεπιστήμιο της Δρέσδης. Τα ευρήματα επαναφέρουν με ένταση τη συζήτηση για την υπερκατανάλωση αντιβιοτικών και τον κίνδυνο για τη δημόσια υγεία.
Οι ερευνητές ανέλυσαν 96 σύνθετα δείγματα αστικών λυμάτων από την είσοδο του βιολογικού καθαρισμού της Πάτρας
Οι ερευνητές ανέλυσαν 96 σύνθετα δείγματα αστικών λυμάτων από την είσοδο του βιολογικού καθαρισμού της Πάτρας Μικροβιακή αντοχή σε αντιβιοτικά ανιχνεύτηκε στα λύματα της Πάτρας σύμφωνα με τα αποτελέσματα μελέτης του Εργαστηρίου Υγιεινής του Πανεπιστημίου Πατρών σε συνεργασία με το Ινστιτούτο Υδροβιολογίας του Τεχνικού Πανεπιστημίου της Δρέσδης.
Υπενθυμίζουμε ότι η χώρα μας κατατάσσεται πρώτη στην ΕΕ με συνολική κατανάλωση, τόσο στην κοινότητα όσο και στα νοσοκομεία, 28,5 ημερησίων δόσεων ανά 1.000 κατοίκους, όταν ο μέσος όρος της ΕΕ δεν ξεπερνά τις 20 ημερήσιες δόσεις.
Από τα ίδια στοιχεία προκύπτει ότι το 90% της κατανάλωσης αντιβιοτικών γίνεται στην κοινότητα, με τους συντάκτες των σχετικών εκθέσεων να υπογραμμίζουν πως χρειάζεται επιπλέον ενημέρωση και ευαισθητοποίηση του κοινού, ώστε να τεθεί σταδιακά το πρόβλημα υπό αποτελεσματικό έλεγχο και να περιοριστεί η αντοχή των σούπερ μικροβίων.
Διαβάστε επίσης: Ο Πατραϊκός ξανά στο επίκεντρο για έρευνες υδρογονανθράκων

Απόστολος Βανταράκης
«Η μικροβιακή αντοχή αποτελεί σήμερα μία από τις σημαντικότερες απειλές για τη δημόσια υγεία παγκοσμίως. Ολο και περισσότερα βακτήρια αναπτύσσουν μηχανισμούς που τα βοηθούν να επιβιώνουν απέναντι στα αντιβιοτικά, με αποτέλεσμα ορισμένες λοιμώξεις να γίνονται δυσκολότερες στη θεραπεία» σημειώνουν ο καθηγητής Υγιεινής του Ιατρικού Τμήματος του Πανεπιστημίου Πατρών Απόστολος Βανταράκης και η υπ. διδάκτορας του Τμήματος Ζωή Αναστοπούλου οι οποίοι διενήργησαν και τη σχετική μελέτη στα λύματα της Πάτρας.
Ειδικότερα οι ερευνητές ανέλυσαν 96 σύνθετα δείγματα αστικών λυμάτων από την είσοδο του βιολογικού καθαρισμού της Πάτρας, σε διάστημα ενός έτους, από τον Σεπτέμβριο του 2022 έως τον Αύγουστο του 2023. Οπως εξηγούν οι ίδιοι, στόχος ήταν να εντοπιστούν συγκεκριμένα γονίδια αντοχής στα αντιβιοτικά, δηλαδή γενετικά ίχνη που συνδέονται με βακτήρια ανθεκτικά σε φάρμακα, και να μελετηθεί η πορεία τους μέσα στον χρόνο. Παράλληλα, η ερευνητική ομάδα διερεύνησε και τη σχέση αυτών των δεικτών με το ιικό φορτίο του SARS-CoV-2 στα ίδια λύματα.

Η Ζωή Αναστοπούλου
Τα αποτελέσματα έδειξαν ότι «στα λύματα της πόλης ανιχνεύθηκαν σταθερά αρκετοί δείκτες αντιβιοτικής αντοχής. Ορισμένα γονίδια που προσδίδουν αντοχή σε αντιβιοτικά όπως κινολόνες (qnrS1) και σουλφοναμίδες (sul1) εμφανίστηκαν σε υψηλότερα επίπεδα σε σχέση με άλλα και επιπλέον σημαντικό γονίδιο που συνδέεται με τη μεταφορά γονιδίων αντοχής μεταξύ βακτηρίων (int1), ήταν επίσης παρόν. Ανιχνεύτηκε, επίσης, η σταθερή παρουσία γονιδίων που προσδίδουν αντοχή σε αντιβιοτικά όπως οι τετρακυκλίνες (tetW) και σε μακρολίδια, όπως η ερυθρομυκίνη (ermB)».
Επίσης ένα άλλο σημαντικό στοιχείο, το οποίο προέκυψε από την έρευνα, είναι ότι «τα γονίδια αντοχής δεν παρέμεναν σταθερά καθ’ όλη τη διάρκεια του έτους. Αντίθετα, παρουσίασαν σαφή εποχική διακύμανση, με υψηλότερες τιμές τους ψυχρότερους μήνες και χαμηλότερες το καλοκαίρι. Η εικόνα αυτή ενδέχεται να σχετίζεται με την αυξημένη χρήση αντιβιοτικών τον χειμώνα, όταν είναι συχνότερες οι λοιμώξεις του αναπνευστικού, αλλά και με περιβαλλοντικούς ή δημογραφικούς παράγοντες».
Βέβαια στην περίπτωση της Πάτρας, οι ερευνητές σημειώνουν ότι η εποχική μείωση μπορεί να συνδέεται και με τη μετακίνηση μεγάλου μέρους του πληθυσμού τους θερινούς μήνες, ιδιαίτερα των φοιτητών και των κατοίκων που απουσιάζουν λόγω διακοπών.
Πολύτιμες πληροφορίες
Η μελέτη ανέδειξε επίσης μια θετική συσχέτιση ανάμεσα στο ιικό φορτίο του SARS-CoV-2 και σε ορισμένους δείκτες Μικροβιακής Αντοχής. «Αυτό δεν σημαίνει ότι ο κορονοϊός προκαλεί άμεσα αντιβιοτική αντοχή. Υποδηλώνει όμως ότι σε περιόδους έντονης κυκλοφορίας του ιού ενδέχεται να αυξάνονται ταυτόχρονα και άλλες πιέσεις στο σύστημα υγείας και στην κοινότητα, όπως η μεγαλύτερη κατανάλωση αντιβιοτικών ή η αυξημένη παρουσία ανθεκτικών μικροβίων στα λύματα».
Καταλήγοντας, ο κ. Βανταράκης και η κ. Αναστοπούλου υπογραμμίζουν: «Υπάρχει σημαντική διασπορά στη μικροβιακή αντοχή στην κοινότητα η οποία αποδεικνύεται μέσω των λυμάτων. Τα αστικά λύματα μπορούν να προσφέρουν πολύτιμες πληροφορίες όχι μόνο για την παρακολούθηση ιών, αλλά και για την έγκαιρη ανίχνευση της Μικροβιακής Αντοχής στην κοινότητα. Η συστηματική παρακολούθησή τους μπορεί να αποτελέσει ένα σημαντικό εργαλείο πρόληψης και δημόσιας υγείας, βοηθώντας τις Αρχές να εντοπίζουν τάσεις, να αξιολογούν κινδύνους και να σχεδιάζουν πιο στοχευμένες παρεμβάσεις για το μέλλον».
Η μελέτη είναι ήδη υπό δημοσίευση σε επιστημονικό περιοδικό.
Η «Πελοπόννησος» και το pelop.gr σε ανοιχτή γραμμή με τον Πολίτη
Η φωνή σου έχει δύναμη – στείλε παράπονα, καταγγελίες ή ιδέες για τη γειτονιά σου.
Ακολουθήστε μας για όλες τις ειδήσεις στο Bing News και το Google News






